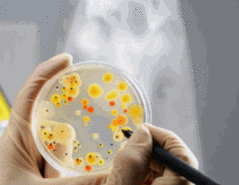

RESOURCES
NIH Guidelines
CDC/NIH Guidelines for Biosafety in Microbiology Laboratory
Select Agents
Centers for Disease Control and Prevention
American Biological Safety Association (ABSA)
Centers for Disease Control (CDC) Home page
CDC Primary Containment for Biohazards; Biological Safety Cabinets
NIH Guidelines on Recombinant DNA Modules
World Health Organization (WHO) Biosafety Manual
Institutional Biosafety Committee (IBC)
Office of Regulatory Research Compliance
Office of Regulatory
Research Compliance
Howard University
Manhattan Bldg.
1328 Florida Ave. NW
Washington, D.C. 20009
Phone: (202)-865-8597
ORRC is located on the
second floor of the Manhattan
Building.